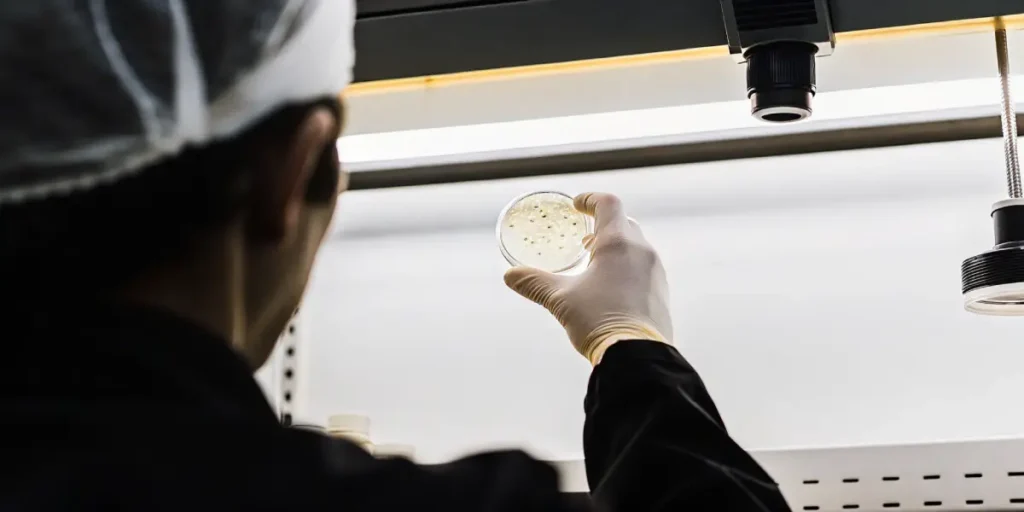
Researcher holding a petri dish with visible cultures under a sterile lab hood.

Discover the Best Proven Stabilized Strains for Your Garden
Gardening enthusiasts know the importance of choosing the right strains for a bountiful harvest. Stabilized strains are the go-to option for many, promising consistent results. Whether you’re new to cannabis cultivation or a seasoned grower, selecting the best strains is crucial.
These cannabis varieties have been bred to express specific traits over several generations. This means they are reliable, offering predictable growth patterns, flavor profiles, and effects. They are invaluable for those looking to maximize their garden’s potential.
Recommended Strains
OG Kush
|
|
THC | 20% - 24% (High) |
|
|
Type | Feminized |
|
|
Yield | Medium |
|
|
Phenotype | 55% Indica / 45% Sativa |
Girl Scout Cookies
|
|
THC | 18% - 25% (High) |
|
|
Type | Feminized |
|
|
Yield | High |
|
|
Phenotype | 60% Indica / 40% Sativa |
For first-time cannabis seed buyers, this world might seem daunting. However, with the right guidance, anyone can master the art of selecting and cultivating these robust plants. Let’s delve into some of the top choices from Blimburn Seeds.
Why Choose Stabilized Strains?
Stabilized strains are a blessing for growers who seek consistency. These strains have been rigorously bred to ensure that plants grow with uniform characteristics. This takes away much of the guesswork associated with cannabis cultivation, allowing growers to predict outcomes with greater accuracy.
One of the major benefits of choosing consistent, reliable genetics is the peace of mind it offers. When you know what to expect in terms of plant size, yield, and flowering time, planning your grow becomes much more straightforward. This predictability is particularly beneficial when you aim to cultivate multiple plants simultaneously.
Moreover, dependable genetics allow for greater control over the final product. Knowing the exact cannabinoid and terpene profiles can aid in achieving the desired effects, whether for medicinal or recreational purposes. This level of control over specific characteristics is what makes these genetics a staple in many gardens.
Beyond cannabis, the concept of stabilization is applied in other fields such as stabilized probiotic strains benefits, providing consistent health advantages. Just like in gardening, the predictability offered by stabilization is invaluable in ensuring the quality and efficacy of probiotic products.
Promos & Deals
Key Traits of Stabilized Strains
Stabilized strains are designed to offer reliable traits, which are consistent across all plants grown from the same seeds. This consistency is achieved through a meticulous breeding process. By selecting plants that exhibit the desired traits and breeding them over several generations, stable genetics are achieved.
These strains are not just about reliability. They also offer delightful flavors and potent effects. When choosing your seeds, it’s essential to consider what you want from your plants. Do you prefer a mellow high or something more intense? Are you looking for specific aromas or flavors?
The predictability of well-bred cannabis varieties extends to their resilience against environmental stressors. These plants have been selectively developed to withstand common issues such as pests and diseases, making them an excellent choice for growers looking to maintain a healthy garden with minimal intervention.
Additionally, the consistency of these varieties allows for experimentation in other areas. For instance, specialized yeast strains for baking enjoy similar benefits, providing consistent rise and texture to baked goods. This level of control is what makes carefully refined genetics so appealing in various applications.
Blimburn Seeds’ Top Stabilized Strains
One standout from Blimburn Seeds is the Girl Scout Cookies. Known for its rich flavor and potent effects, this strain is a favorite among growers. Its stabilized genetics ensure it consistently delivers a sweet, earthy aroma with a touch of mint.
Blue Dream is another excellent option, offering a balance between relaxation and euphoria. This strain’s stabilized characteristics make it a top choice for those seeking a reliable and easy-to-grow plant. Blue Dream’s fruity and sweet aroma is a delight for the senses.
Another remarkable choice from Blimburn Seeds is the stabilized hybrid seed strain, which combines the best attributes of various cannabis types. These hybrids are meticulously bred to ensure stability, resulting in robust plants that maintain their unique properties across generations.
For those looking for classic strains, the OG Kush remains a cornerstone. Its stabilized genetics guarantee a consistent experience, with each plant producing a similar yield and potency. This reliability makes it a go-to option for many seeking a tried-and-true strain.
How to Make the Most of Stabilized Strains
Maximizing the potential of stabilized strains involves a few key steps. First, ensure your growing environment is optimal. This means maintaining the right temperature, humidity, and light conditions. A stable environment will complement the stable genetics of your strains.
Another important aspect is nutrient management. Your plants still require proper feeding to thrive. Make sure to use high-quality nutrients and follow recommended feeding schedules. This will ensure your plants have everything they need to reach their full potential.
Besides environmental control and nutrient management, knowing how to stabilize cannabis strains can further enhance your cultivation efforts. By selectively breeding plants with desired traits, you can develop varieties that align perfectly with your growing conditions and personal preferences.
Finally, consider integrating technology, such as automated watering systems or climate control tools, to maintain optimal conditions. These investments can pay off by ensuring your plants perform at their best, leading to a more successful and stress-free growing season.
FAQs about stabilized strains
What are the benefits of stabilized strains?
Stabilized strains offer several benefits, primarily consistency. This means you can expect uniform growth, yield, and effects from plants grown from the same batch of seeds. This is particularly advantageous for those aiming to cultivate multiple plants with similar characteristics.
Additionally, these strains often boast enhanced flavors and aromas. By selecting stable genetics, breeders can focus on refining specific traits, resulting in plants with distinctive and desirable profiles. This makes them a favorite among both new and experienced growers.
For cultivators interested in other applications, exploring the best stabilized bacterial strains for fermentation can open new avenues. These strains provide consistent and reliable results, similar to their cannabis counterparts, making them invaluable in producing high-quality fermented products.
Furthermore, stabilized strains can be particularly beneficial in medical applications, where consistency in cannabinoid content is crucial for patient treatment plans. This reliability ensures patients receive the same therapeutic effects with each use, enhancing the overall effectiveness of their regimen.
How can I stabilize my cannabis strains?
Stabilizing cannabis strains involves a process of selective breeding. By choosing plants that exhibit the desired traits and breeding them over several generations, stable genetics can be achieved. This process requires patience and a keen eye for detail.
For those interested in breeding their own stabilized strains, it’s essential to start with high-quality genetics. From there, you can begin selecting plants that best exhibit the traits you’re aiming for, repeating the process until the desired stability is achieved.
The art of how to stabilize cannabis strains is both a science and a craft. It involves knowing genetics, observing plant characteristics, and making informed breeding decisions. This meticulous process can lead to the creation of unique strains tailored to specific needs.
Additionally, leveraging advanced techniques such as genetic testing can accelerate the stabilization process. By identifying genetic markers associated with desired traits, breeders can make more precise selections, leading to faster and more reliable stabilization outcomes.
What about stabilized hybrid seed strains?
Stabilized hybrid seed strains combine the best traits of different cannabis varieties. These hybrids are bred to offer unique characteristics, such as specific flavors, effects, or growth patterns. The stabilization process ensures these traits are reliably expressed in each plant.
For growers, this means enjoying the benefits of hybrid vigor, which often results in more robust and resilient plants. Stabilized hybrids are an excellent choice for those seeking the best of both worlds in their garden.
Blimburn Seeds offers a variety of stabilized hybrid seed strains, each crafted to deliver distinctive qualities. These strains provide growers with the opportunity to explore diverse flavors and effects, all while maintaining the reliability that comes with stabilization.
Moreover, hybrid strains can offer enhanced adaptability to varying climates and growing conditions. By selecting strains with complementary characteristics, breeders create hybrids that thrive in diverse environments, making them suitable for a wide range of growers.
Are stabilized strains suitable for beginners?
Absolutely! Stabilized strains are ideal for beginners due to their predictability and ease of growth. These strains provide a more straightforward growing experience, making them perfect for those new to cannabis cultivation.
With stabilized strains, beginners can focus on learning the basics of cultivation without the added challenge of unpredictable plant behavior. This makes them an appealing choice for anyone starting their growing journey.
For novice growers, choosing stabilized strains from reputable sources like Blimburn Seeds can significantly enhance their initial experiences. These strains offer a forgiving nature, allowing beginners to experiment and learn without facing overwhelming challenges.
Additionally, the confidence gained from successfully cultivating stabilized strains can inspire beginners to explore more advanced growing techniques. As they become more experienced, they can gradually diversify their garden with different varieties, including hybrids and rare strains.
Can stabilized strains be used for other purposes?
Stabilized strains are not limited to cannabis cultivation. The concept of stabilization is used in various fields, such as in creating stabilized probiotic strains for health benefits or stabilized yeast strains for baking. The principle remains the same: ensuring consistent and reliable results.
Furthermore, stabilized bacterial strains are used in fermentation processes, highlighting the versatility of this concept. Whether for gardening or other applications, stabilization offers reliability and quality, making it a valuable tool in various industries.
In the culinary world, stabilized yeast strains for baking ensure uniform texture and flavor, crucial for producing high-quality bread and pastries. Similarly, stabilized probiotic strains benefits include consistent health advantages in supplements, providing reliable gut health support.
The stabilization process is also pivotal in agricultural research, where developing stable crop varieties can lead to improved yields and resilience. Across these diverse applications, stabilization remains a cornerstone for innovation and excellence.


